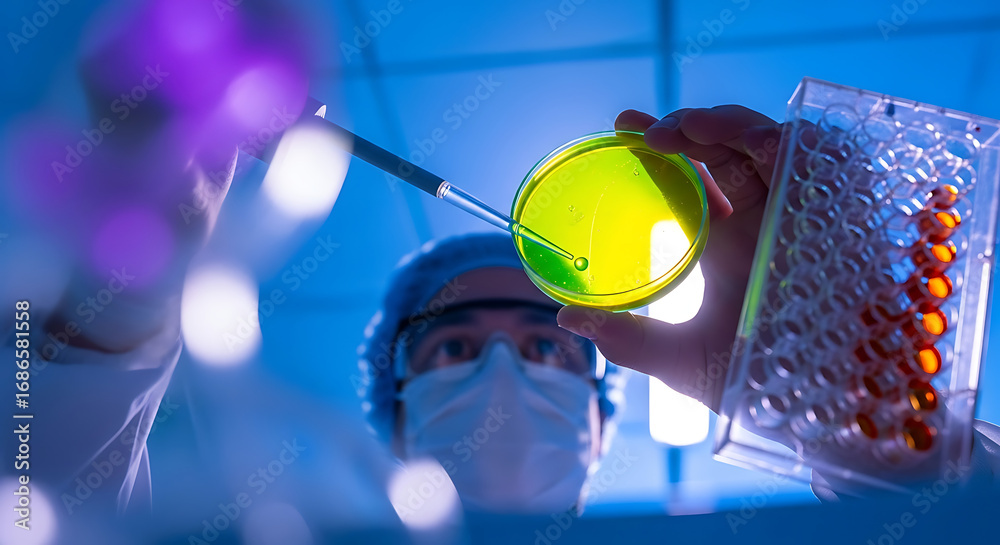

-
Marche & Merch
- Poster cinema
- Batman
- Uomo Ragno
- Star Wars
- Harry Potter
- MARVEL
- DISNEY
- Pokémon
- Mostra tutti
- Musica
- Queen
- Rolling Stones
- AC/DC
- I Beatles
- Bob Marley
- Iron Maiden
- Metallica
- Mostra tutti
- Anime & Manga
- L'attacco dei giganti
- Pokémon
- Demon Slayer
- Jujutsu kaisen - Sorcery Fight
- Death Note
- Dragon Ball Z
- My Hero Academia
- Mostra tutti
- Fumetti
- Batman
- Uomo Ragno
- Superman
- Capitan America
- Vendicatori
- MARVEL
- Wonder Woman
- Mostra tutti
- Videogiochi
- Assassin's Creed
- Nintendo
- Playstation
- Giochi online
- Xbox
- Minecraft
- Sonic
- Mostra tutti
- Poster per bambini
- Harry Potter
- Minecraft
- Lilo & Stitch
- DISNEY
- Il regno di ghiaccio
- Topolino
- Principesse
- Mostra tutti
-
Illustrazioni
- Per soggetto
- Illustrazioni astratte
- Toni in bianco e nero
- Poster di viaggio
- Detti e citazioni
- Tocco di natura
- Collage
- Line Art
- Man Cave
- Moda
- Motivi per bambini
- Romantici
- Illustrazioni sportive
- Magazine Cover
- Women Power
- Animali
- Ispirazioni quotidiane per la tua casa o ufficio
- Per stile
- Bauhaus
- Stile ecologico
- Retro & Vintage
- Atmosfera asiatica
- Stile scandinavo
- Stile Art Deco
- Stile bohémien
- Eleganza parigina
- Paradiso Tropicale
- Stile pop art
- Stile provenzale
- Armonia e calma
- Stile castello romantico
- Stile industriale
-
Quadri & Tele
- Stampa su tela
- Stampa su tela
- Tele Componibili
- Stampa su tela -60 %%
- Mostra tutti
- Quadri & Tele
- Incorniciatura: Cornici e Ganci
- Poster con cornice -20 %%
- Stampa su tela con foto
- Riproduzioni
- Tele Componibili
- Riproduzioni
- Florent Bodart
- Paul Cézanne
- Claude Monet
- Pierre-Auguste Renoir
- Sam Toft
- Leonardo da Vinci
- Alfons Mucha
- Hieronymus Bosch
- Gustav Klimt
- Wassily Kandinsky
- Leonetto Cappiello
- Vincent van Gogh
- Katsushika Hokusai
- Mostra tutti
-
Foto
- Per soggetto
- Eleganza del Bianco&Nero
- Animali
- Natura & Paesaggio
- Viaggio attorno al mondo
- Prova d'Amore
- Momenti della vita quotidiana
- Macro
- Avventura esotica
- Bellezza minimalista
- Old school
- Poster panoramici
- Mondo Appetitoso
- Emozioni di montagna
- Vista dall’alto
-
Poster
- Incorniciatura: Cornici e Ganci
- Cornici già pronte
- Listelli per poster
- Accessori
- Decorazioni sulle pareti
- Cartelli in metallo
- Set di poster
- Poster / Fotomurali per porte
- Adesivi per mobili
- Poster giganti
- Poster panoramici
- Poster con cornice -20 %%
- Marche & Merch
- Poster cinema
- Musica
- Anime & Manga
- Fumetti
- Videogiochi
- Poster per bambini
- Sport
- Celebrità
- Poster
- Più Venduti - TOP
- Novità
- Stampa delle foto
- Marche & Merch
- Ultima occasione -60%%
- Saldi fino a -80 %%
- Decorazioni sulle pareti
- Incorniciatura: Cornici e Ganci
- Motivi
- Animali
- Architettura
- Arte astratta
- Auto - Moto - Aeronautica
- Bandiere
- Bianco & Nero - Black & White
- Celebrità
- Cibo & bevande
- Fantasy & Mystery
- Feste, Celebrazioni, Vacanze
- Illustrazioni
- Mappe & Planisfero
- Metropoli & Città
- Moda
- Motivazionali & Citazioni
- Natura & Paesaggio
- Per le Imprese
- Poster divertenti
- Poster educativi - Scuola
- Poster erotici
- Riproduzioni
- Romantici
- Sport
- Storia e religione
- Universo
- Viaggi
-
Fotomurali
- Fotomurali -60 %%
- I preferiti
- Adesivi
- Scelti dal Designer
- Fotomurali cinema
- Supereroi
- Animate
- Serie TV
- Fantasy
- Fotomurali per soggetto
- Auto - Moto - Aeronautica
- Universo
- 3D Poster & 3D Carta da Parati
- Architettura
- Temi di gioco
- Fotomurali musicali
- Mappe del mondo
- Motivi per bambini
- Natura & Paesaggio
- Fotomurali artistici
- Modelli e ornamenti
- Animali
-
-20 %Calendari 2026
- Calendari - Animali
- Calendari - Artisti
- Calendari - Auto, Moto & Veicoli
- Calendari - Città
- Calendari - Erotici
- Calendari - Film e serie TV
- Calendari - Musica
- Calendari - Personaggi Famosi
- Calendari - Retro & Vintage
- Calendari - Spirituali
- Calendari - Sport
- Calendari - Viaggi
- Calendari - Videogiochi
- Calendari 3D
- Calendario Avvento
- Calendari - Animali
- Calendari - Artisti
- Calendari - Auto, Moto & Veicoli
- Calendari - Città
- Calendari - Erotici
- Calendari - Film e serie TV
- Calendari - Musica
- Calendari - Personaggi Famosi
- Calendari - Retro & Vintage
- Calendari - Spirituali
- Calendari - Sport
- Calendari - Viaggi
- Calendari - Videogiochi
- Calendari 3D
- Calendario Avvento
- Mostra tutti
-
Tazze & Stoviglie
- Stoviglie
- Astucci metallici & Porta pranzo
- Borracce
- Apribottiglie
- Sottobicchieri
- Bicchieri
- Bicchieri da Shot
- Stoviglie & Tazze
- Stoviglie a tema
- Anime piatti
- Stoviglie Auto-moto
- Stoviglie retrò
- Stoviglie di artisti famosi
- Piatti Fantasy
- Film e serie TV
- Foto
- Tazze videogiochi
- Tazze per bambini
- Musica
- Fumetti
- Stoviglie sportive
- Humor piatti
- Novità
-
Abbigliamento
- Abbigliamento
- Felpe con cappuccio & Maglioni
- Berretti & cappelli
- Abbigliamento invernale
- Calze
- Pantaloni
- Pigiami ed accessori per dormire
- Accappatoi & Asciugamani
- Borse & Zaini
- Portafogli
- Gioielli e accessori di bellezza
- Ombrelli
- Manicotti da gaming
- Biancheria
- Novità
- Magliette & Top
- Magliette da donna
- Magliette da uomo
- Magliette da bambino
- T-shirt – La nostra collezione
- T-shirt con foto
- Magliette -60 %%
- T-shirt per marca
- Magliette musicali
- Magliette anime
- Magliette film e TV
- Magliette gaming
- Harry Potter
- Star Wars
- Il signore degli anelli
- MARVEL
- Batman
- Magliette per tema
- Magliette con artisti famosi
- T-shirt con motivi sportivi
- Magliette astratte
- T-shirt con motivi asiatici
- T-shirt Line Art
- T-shirt cibo & bevande
- T-shirt con animali
- T-shirt Auto Moto
- T-shirt con motivi per bambini
- T-shirt con bandiere
- Magliette divertenti
- Magliette con citazioni
- Magliette Bauhaus
- Magliette Pop Art
- Sostieni l'Ucraina
-
Magliette & Top
- Felpe con cappuccio & Maglioni
-
Berretti & cappelli
-
Abbigliamento invernale
- Calze
- Pantaloni
- Pigiami ed accessori per dormire
- Accappatoi & Asciugamani
-
Borse & Zaini
-
Portafogli
-
Gioielli e accessori di bellezza
- Ombrelli
- Manicotti da gaming
-
Moda per tema
-
Abbigliamento per:
- Biancheria
- Novità
- Mostra tutti
-
 T-shirt – La nostra collezione
T-shirt – La nostra collezione
 Magliette da donna
Magliette da donna
 Magliette da uomo
Magliette da uomo
 Magliette musicali
Magliette musicali
 Magliette film e TV
Magliette film e TV
 Magliette gaming
Magliette gaming
-
Regali & Giochi
- Regali & Giochi
- Giocattoli
- Idee Regalo
- Regali fotografici
- Regali perfetti per
- Natale
- Regali per uomini
- Regali per le donne
- Regali per bambini
- Regali per coppie
- Regali per collezionisti
- Regali per giovani studenti
- Regali per animali
- Merch
- Accessori per la casa
- Cartelli in metallo
- Set regalo
- Regali piccoli & economici
- Statuette
- Repliche da collezione
- Giocattoli
- Tazze & Stoviglie
- Calendari 2026 -20 %%
- Cancelleria ufficio & scuola
- Regali retro in latta
- Puzzles
- Borse & Zaini
- Quaderni
- Materiali artistici
- Poster con cornice -20 %%
- Giocattoli
- Bambole
- MGA's Miniverse
- LEGO
- Peluches
- Action figures e giocattoli
- Modellini di auto
- CarTuned
- Hot Wheels
- Carte da gioco
- NERF
- Giochi da tavolo
- Cubi con immagini
-
Per le Imprese
- Per le Imprese
- Bellezza e benessere
- Studio nuziale
- Accoglienza
- Medici
- Poster educativi - Scuola
- Studio di fitness
- Eroi di strada
- Ufficio
- Esperti e uomini d'affari
- B2B Partners
- Bellezza e benessere
- Salone di Bellezza
- Studio di tatuaggi
- Barbiere
- Benessere e SPA
- Parrucchiere
- Nail studio
- Studio di fitness
- Fitness & Palestra
- Estetica sportiva
- Illustrazioni sportive
- Automobilist
- Yoga
- Danza
- Calcio
- Cornici & Incorniciatura
- Regali fotografici
Il poster non contiene filigrane o #numero di serie.


i colori della stampa potrebbero leggermente differire da quelli che appaiono sul vostro schermo.
Foto Scientist working with cell culture in laboratory for medical research and devel Pixel Prism
 4.7 3 816 recensioni
4.7 3 816 recensioni
Scegli altre opzioni di stampa
Descrizione del Prodotto
Foto
Le illustrazioni e le fotografie sono stampate su carta fotografica lucida premium con grammatura di 250 g/m². La sua superficie liscia e lucida offre un'eccellente chiarezza e nitidezza, migliorando il contrasto e la saturazione dei colori, rendendola adatta a fotografie e immagini ad alta risoluzione. La superficie lucida ha il vantaggio di essere meno soggetta ai segni del tatto.Offriamo molti formati standard, che potete anche personalizzare per combinarli meglio con gli altri. Oltre ai formati standard, offriamo anche cornici perfettamente aderenti, per rendere completa la vostra immagine!


Qualità artigianale e consegna veloce
La qualità viene sempre prima di tuttoLa meticolosa produzione artigianale di ogni stampa nella Repubblica Ceca non è solo il nostro orgoglio, ma anche il miglior biglietto da visita che fa sì che i nostri clienti tornino da noi. Trattiamo ogni stampa individualmente, ne controlliamo sempre la qualità e la imballiamo in modo sicuro in modo che non venga danneggiata durante il suo viaggio verso di te.
Stampiamo il giorno stesso!
Tu ordini e noi iniziamo a stampare il giorno stesso. Spediamo tutti i tipi di stampe entro 48 ore dall'ordine.
Aggiungere un bordo bianco o nero all'immagine
Se si desidera che il motivo scelto risulti più chiaro sulla parete, è possibile far stampare l'immagine con un bordo bianco o nero.Il bordo funge da contorno e incornicia visivamente l'immagine lungo il suo perimetro. Viene calcolato automaticamente per ogni dimensione scelta.
Non potrete sbagliare con una montatura e le vostre immagini avranno un aspetto professionale, inoltre il bordo sarà perfetto nella cornice!
Recensioni dei clienti ed esperienze

4.7 / 5
(3 816 recensioni)
Recensioni visualizzate per: Foto
Partecipa al concorso fotografico su Instagram e vinci un buono di 40€!


1. Carica la tua foto su Instagram.
2. Tagga il nostro profilo:
@europosters.merch.
3. Vinci!
Un vicitore viene estratto ogni mese. In bocca al lupo!
Contatti
FAQ
La nostra missione
Pagamento e spedizione
Condizioni generali di vendita
Termini di restituzione
Informativa sulla privacy
Promozioni e sconti
Programma di fedeltà
Le vostre recensioni
Cornici & Incorniciatura
Adesivi
Collaborazioni
Per artisti e fotografi
Per influencer e affiliati
Per band e altri brand
Per partner B2B
Europosters – Decora la tua vita
Dal 1999, Europosters è uno dei più grandi eshop nella Repubblica Ceca e in tutta l’Europa per quanto riguarda poster, stampe da parete e articoli da regalo con licenza. Offriamo una vasta selezione di poster cinema, giochi o sport di tutte le dimensioni, nonché un'ampia scelta di regali originali per i veri fan di Star Wars, Harry Potter, fumetti o l'intera famiglia Warner Bros. Sappiamo che tazze, statuine, puzzle e vestiti sono il miglior regalo per tutti, indipendentemente dall'età o dall'interesse. Ma se sei un appassionato di home deco, allora sei nel posto giusto anche tu! Ogni giorno stampiamo murales, illustrazioni, fotografie e riproduzioni d'arte e li inviamo in più di 25 paesi per soddisfare i nostri clienti.
Contatti:
E-mail: info@europosters.eu
Telefono: +420 210 440 210 (in inglese)
Lunedi – Venerdì ǀ 7:00–17:00
© 1999–2025 Europosters. Tutti i diritti riservati.
Premiamo i nostri clienti fedeli!
Registrandovi accettate la nostra policy sulla privacy..






























































 Selezionato
Selezionato















